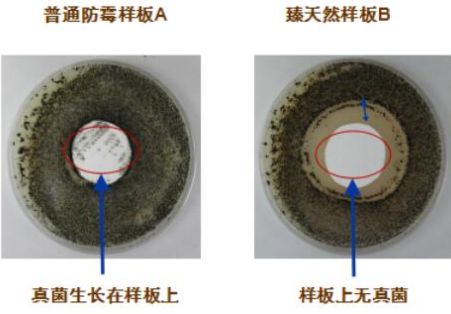

长颈鹿牌臻天然抗病毒无机矿物涂料强势出道!
今年,随着新冠病毒的疯狂肆虐,疫情快速席卷全球多个国家和地区,成为当前全世界人类共同面临的紧急重大公共卫生难题,其中关于室内空间健康问题也成为了人们的关注重点。
在疫情的严重影响下,无论是家居室内装修,还是公共场所室内装修,人们在选择墙面涂料时,除了秉持以往的高环保标准和净味需求,也更倾向于选择那些具备抗病菌功效,能为室内空间健康提供更高保障的涂料产品。
作为拥有88载专业制漆经验的实力企业,中华制漆坚持以客户为中心,顺势推出长颈鹿牌臻天然抗病毒无机矿物涂料新品,满足人们挑剔的涂料选购需求,用实力征服消费者,为更多场所的健康安全保驾护航!

长颈鹿牌臻天然抗病毒无机矿物涂料
抗病毒抗菌, 双重实力派
秉持一如既往的高品质生产标准,长颈鹿牌臻天然抗病毒无机矿物涂料由中华制漆技术团队潜心研发,在原先的无机矿物涂料配方上再度升级,甄选环保天然材料,采用独有的制漆工艺专利技术,反复调整制样,层层把控生产、检验、出厂各个环节,全方位实现抗病毒抗菌功效的持久作用。

臻天然抗病毒无机矿物涂料独有的科学配方中,各组分之间达到良好的相容性。在保证涂料气味、质感及各种功效稳定的前提下,产品结合创新杀毒灭菌技术,快速破坏病菌核酸结构,使核酸物质变性,从而高效杀灭病菌,抑制病菌的滋生繁殖。在日后对墙面的防护中,产品也将持续发挥抗病菌功效,保持墙面持久清洁健康。
经国内权威微生物检测机构分别对产品抗病毒性能和抗菌性能进行了严苛检测,其实验数据表明,臻天然抗病毒无机矿物涂料对甲型流感病毒(H3N2)、肠道病毒71型(引起手足口病的一种病毒)、大肠杆菌、金黄色葡萄球菌等病菌具有99.99%的超高灭活率,属于可检测的最高级别杀灭率,相较其它普通的装修涂料,该产品拥有更稳定更出色的抗病菌功效。

*病毒灭活率达99.99%

*抗菌性能达到最高标准要求I级
抗病毒抗菌功效随着墙面涂层的存在,不仅维持时间长,而且可针对生活中常见的多种病菌类型发挥作用。病菌在公共场所墙面存活时间久,加上大量繁殖蔓延,影响人们身体健康,选择在家居及公共场所内墙涂装中使用长颈鹿牌臻天然抗病毒无机矿物涂料,提升室内空间“免疫力”,无疑是对场所健康防护的更好选择。
天然无机,低碳环保
长颈鹿牌臻天然抗病毒无机矿物涂料取材于天然无机矿物,不含有害物质,从原材料获取、生产加工到使用的过程中,对环境不产生污染物质,其成膜拥有无机矿物涂料的天然气味,对人体健康无危害,属于不可多得的低碳环保、生态友好型墙面涂料。
防霉抗藻,性能卓越
在防霉抗藻性能方面,长颈鹿牌臻天然抗病毒无机矿物涂料的优异性遥遥领先于普通防霉涂料,符合0级防霉标准。凭借自身呈高碱性的无机矿物成分,霉菌在此条件下难以存活,加之所成漆膜拥有绝佳的透气性,该产品无需添加化学抗菌剂和防霉剂,便具备天然的抵抗霉菌藻类生长的能力,达到对墙面防霉、防潮、防藻的更持久、更全面的防护效果。
防火抗燃,极耐高温
臻天然抗病毒无机矿物涂料具有良好的防火抗燃性,可达到A级防火材料要求。在高温灼烧下,能阻隔明火与基材的接触并降低火灾时有害物质的排放,相比于其他胶质涂料,具有更出色的防火抗燃表现,对人们的生命安全更有保障。

*燃烧性能等级为A级
耐久耐候,绝佳透气
该产品涂刷于墙面后,将与墙体牢牢结合,形成坚硬饱满、附着力强的漆膜涂层,新墙无需底漆也可轻易施工使用,具备超强的耐久耐候性。涂层中的微晶结构让漆膜拥有绝佳的透气性能,充分吸收墙面水分,即便在潮湿多雨的季节,也能保持墙体干燥,让人们畅享洁净、舒适的生活环境。
长颈鹿牌臻天然抗病毒无机矿物涂料不仅通过国家权威检验机构专业检验,在性能、安全及抗病菌防霉等多个项目的检验结果均超行业标准,同时取得中国环境标志产品十环认证标志,属于质量优异、绿色环保产品。凭借自身拥有的多方面性能优势,长颈鹿牌臻天然抗病毒无机矿物涂料不仅适用于家居墙面涂装,还可在酒店、餐厅、学校、医院、超市、地下车库等众多公共场所中充分使用。

长颈鹿牌臻天然抗病毒无机矿物涂料的强势出道,是中华制漆在技术和产品上的再一次创新。即便在疫情影响下,公司也将继续坚持以市场为导向,以客户为中心,不断提高技术创新能力和产品质量,持续为建筑空间注入健康生命力,为客户提供更优质的产品和服务,创造更具价值的全场景涂装解决方案。
网址:长颈鹿牌臻天然抗病毒无机矿物涂料强势出道! https://c.jiaju82.com/news-view-id-745776.html

